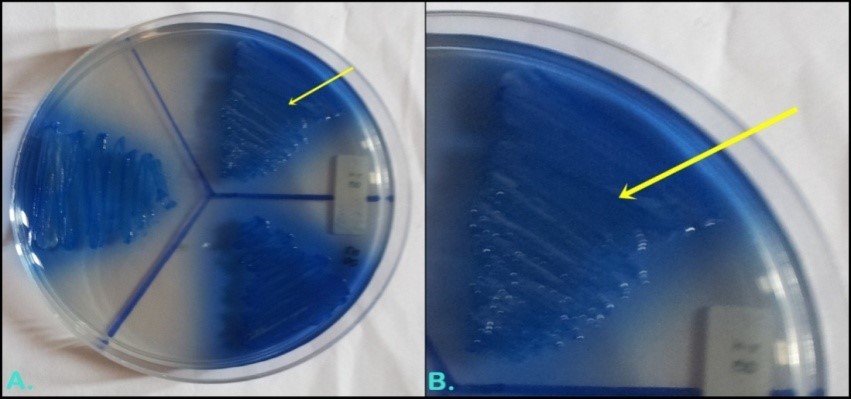

Staphylococcus aureus (S. aureus) merupakan tumbuhan normal yang memiliki sifat patogen oportunistik. Individu sehat yang memiliki kolonisasi S. aureus disebut sebagai karier. Mukosa hidung dikatakan sebagai sumber utama penularan dari S. aureus dengan kolonisasi sekitar 20% pada anjing. Infeksi S. aureus merupakan salah satu masalah kesehatan masyarakat yang penting, karena kasus infeksi cenderung meningkat setiap tahun. Salah satu cara mengatasi masalah infeksi S. aureus adalah dengan penggunaan antibiotik. Intensitas penggunaan antibiotik yang terus meningkat dan secara irasional menimbulkan masalah yaitu munculnya jenis S. aureus yang resisten terhadap antibiotik disebut dengan Methicillin Resistant Staphylococcus aureus (MRSA).
Penularan dari manusia ke hewan dapat terjadi karena saat ini hewan peliharaan sering dianggap dan diperlakukan sebagai anggota keluarga, sehingga memungkinkan terjadinya kontak fisik antara manusia dan hewan peliharaan yang dapat menyebabkan penularan bakteri. Hal ini tentunya menjadi masalah kesehatan masyarakat yang potensial karena MRSA dari manusia dapat menyebabkan infeksi pada hewan peliharaan, dan hewan peliharaan juga dapat menjadi sumber penularan MRSA pada manusia, sehingga harus kita waspadai bahwa hewan peliharaan dapat berperan sebagai reservoir dalam menularkan infeksi kepada manusia ketika bersentuhan dengan hewan.
Infeksi MRSA pada anjing penting untuk diperhatikan dan diteliti mengingat kesamaan karakteristik gen MRSA yang terdapat pada anjing dengan manusia yang mengindikasikan telah terjadi infeksi, namun mekanisme penularan infeksi tersebut masih belum diketahui secara pasti. Strain MRSA pada anjing jauh lebih resisten terhadap antibiotik daripada strain MRSA pada manusia. Beberapa penelitian telah dilakukan untuk mengetahui resistensi antibiotik dan skrining terhadap MRSA pada manusia, namun penelitian ini belum pernah dilakukan pada anjing di Indonesia. Penelitian tentang uji resistensi antibiotik dan uji skrining MRSA dari usap hidung anjing diharapkan dapat memberikan masukan atau informasi tentang resistensi antibiotik dan skrining MRSA dari anjing.
Hasil isolasi dan identifikasi S. aureus pada 50 sampel usap mukosa hidung anjing didapatkan 24 (48%) sampel positif S. aureus. Beberapa peneliti menyebutkan bahwa infeksi pembawa S. aureus pada anjing berkisar antara 20%, tetapi dapat mencapai 70% -88%. Bakteri S. aureus yang dapat diisolasi dan diidentifikasi dalam penelitian ini semakin menegaskan bahwa hidung anjing mengalami infeksi pembawa dan dapat menjadi sumber penularan infeksi bakteri.
Berdasarkan persentase hasil uji resistensi antibiotik dapat diketahui jika masing-masing asal memiliki resistensi terhadap satu jenis antibiotik, resistensi tertinggi terhadap tetrasiklin terjadi pada sampel S. aureus dari penangkaran anjing Kenjeran dan sebagian besar lokasi pengambilan sampel memiliki resistensi. Menurut Findik et al., S. aureus resistensi terhadap penisilin merupakan hal yang umum, dengan tingkat resistensi hampir 90%. Valentina dan Lestari menulis bahwa dalam komunitas manusia Indonesia, frekuensi resistensi tertinggi adalah terhadap tetrasiklin, sedangkan yang terendah adalah resistensi terhadap oksasilin.
Hasil skrining MRSA yang positif memastikan bahwa anjing yang sehat dapat membawa koloni MRSA tanpa gejala. Faires et al., menyatakan bahwa MRSA dapat diidentifikasi pada anjing sehat tanpa menunjukkan manifestasi klinis. Kolonisasi MRSA tidak akan menyebabkan penyakit serius jika terjadi pada manusia dan hewan dengan kondisi normal (sehat), namun akan menyebabkan penyakit serius yang mengancam jiwa jika terjadi pada individu yang memiliki imunitas rendah. Penularan MRSA pada anjing terjadi melalui kontak langsung dengan bakteri yang ditemukan di sesama hewan, manusia, dan lingkungan yang terkontaminasi.
Interaksi antara hewan dan manusia memiliki peran penting dalam penyebaran MRSA, karena kebanyakan anjing mendapatkan MRSA melalui kontak manusia. Tidak ditemukannya S. aureus pada anjing liar menunjukkan bahwa kontak dengan manusia memiliki peran penting, walaupun masih terdapat faktor lain seperti genetik dan lingkungan yang dapat mempengaruhi penularan infeksi. Berdasarkan penelitian ini, 14 positif MRSA. Grema et al., menyatakan bahwa MRSA pada dasarnya adalah Staphylococcus aureus yang memiliki resistensi terhadap methicillin. Penelitian ini tampaknya sesuai dengan penelitian sebelumnya yang berhasil mengisolasi MRSA pada anjing. Penelitian di Eropa menemukan kecocokan MRSA pada anjing, kucing yang identik dengan pemilik dan hewan peliharaan yang terinfeksi. Dominasi strain MRSA manusia pada hewan peliharaan rumah tangga menunjukkan bahwa hewan terinfeksi melalui kontak dengan orang yang terinfeksi, dan ini menunjukkan bahwa hewan peliharaan dapat menyebarkan kembali MRSA ke manusia atau spesies lain.
Hasil penelitian ini menjelaskan bahwa MRSA terdapat pada sampel usap hidung dari sampel yang sehat. Hal ini sesuai dengan hasil penelitian Faires et al., yang menyatakan bahwa MRSA semakin banyak teridentifikasi pada anjing dan kucing yang mengalami infeksi serta anjing dan kucing yang sehat. Saat ini hewan peliharaan rumah tangga sering dianggap sebagai reservoir. Kontak fisik antara manusia dan hewan peliharaan yang dapat menyebabkan penularan bakteri. Ini merupakan masalah kesehatan yang potensial karena MRSA dari manusia dapat menyebabkan infeksi pada hewan peliharaan, dan hewan peliharaan dapat menjadi sumber MRSA untuk infeksi pada manusia.
Penyebaran MRSA sendiri terjadi baik melalui kontak langsung dengan orang yang terinfeksi atau melalui kontak langsung dengan permukaan atau benda yang sebelumnya terkontaminasi oleh individu yang terinfeksi. Hewan dengan infeksi MRSA dapat berfungsi sebagai reservoir penularan bakteri atau manusia oleh bakteri, oleh karena itu pengendalian dan pencegahan penularan MRSA dari hewan ke hewan, serta dari hewan ke manusia harus dilakukan dengan menerapkan kebiasaan hidup bersih untuk mencegah berjangkitnya bakteri. MRSA pada hewan dan manusia. Pada penelitian ini tingginya persentase isolat MRSA 14/50 (28%) dari total jumlah usap hidung anjing dan 14/24 (58,33%) isolat Staphylococcus aureus di Surabaya sama dengan tingkat resistensi pada isolat klinis tersebut. Data sebelumnya telah dilaporkan oleh banyak penulis: 45,5% di Jepang, 61% di Taiwan, 61,5% di Sudan, dan 61,8% di AS.
Belum ditemukan terapi infeksi MRSA yang efektif, sehingga diperlukan tindakan pengendalian dan pencegahan untuk mengatasi masalah penyebaran MRSA. Program pengendalian dan pencegahan infeksi MRSA dapat dilakukan dengan deteksi dini MRSA dengan pengawasan mikrobiologi, menjaga kebersihan tangan, penyuluhan, penggunaan standar keamanan, penggunaan antibiotik yang rasional, dan ruang isolasi bagi penderita infeksi. Berdasarkan hasil penelitian beberapa uji resistensi antibiotik dan uji skrining MRSA dari usap mukosa hidung anjing, dapat disimpulkan bahwa penelitian mukosa hidung anjing yang memiliki kolonisasi karier MRSA dapat berperan sebagai reservoir untuk penyebaran ke kesehatan manusia, dan setiap lokasi pengambilan sampel memiliki gambaran yang berbeda tentang resistensi antibiotik.
Penulis: Dr. Mustofa Helmi Effendi, drh., DTAPH
Informasi detail dari riset ini dapat dilihat pada tulisan kami di:
Decline V, Effendi MH, Rahmaniar RP, Yanestria SM, Harijani N (2020) Profile of antibiotic-resistant and presence of methicillin-resistant Staphylococcus aureus from nasal swab of dogs from several animal clinics in Surabaya, Indonesia, Int. J. One Health, 6(1): 90-94.
https://www.onehealthjournal.org/Vol.6/No.1/15.html